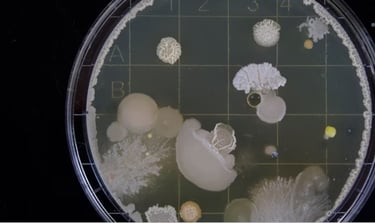

Curiosidades
Informações que talvez te interesse
Bactérias na Bucha de Prato: O Que Você Precisa Saber e Como Se Proteger
A História Encantadora da Aliança de Casamento
Como Utilizar um Japamala na Meditação ou Mantra
Os 20 Nomes Mais Bizarros e Engraçados do Futebol Brasileiro
20 Curiosidades Fascinantes sobre o Futebol
A História Real Por Trás do Marinheiro Popeye
Entendendo a Diferença entre Tornados, Furacões e Ciclones
Como Surgiu a Descoberta da Ansiedade.
Quem quer ser um milionário?
Coisas que Você Não Sabia Sobre o Orgasmo
Por que Usar Creatina? Entenda Seus Benefícios e Limitações